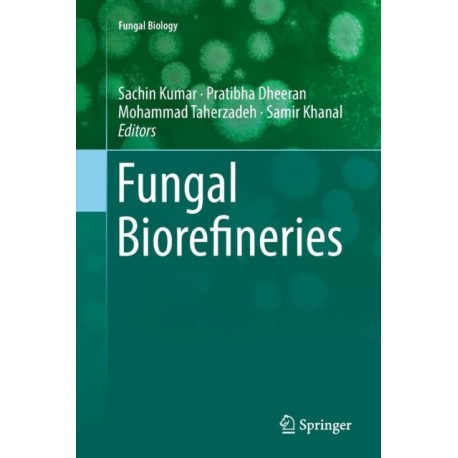

Kurv
Vare
varer
(tom)
Ingen varer
Fastlægges senere
Forsendelse
0,- kr
I alt
Fungal Biorefineries
(Bog, Paperback / softback, Engelsk)
Forlag:
Springer Nature Switzerland AG
- Type: Bog
- Format: Paperback / softback
-
Sprog:
Engelsk

- ISBN-13: 9783030080020
- Se flere detaljer ▼
Bemærk: Kan ikke leveres før jul.
Beskrivelse
This book covers the applications of fungi used in biorefinery technology. As a great many different varieties of fungal species are available, the text focuses on the various applications of fungi for production of useful products including organic acids (lactic, citric, fumaric); advanced biofuels (ethanol, single cell oils);
Læsernes anmeldelser (0)
Alle detaljer
| Forlag | Springer Nature Switzerland AG |
| Type | Bog |
| Format | Paperback / softback |
| Sprog | Engelsk |
| Udgave | Softcover reprint of the original 1st ed. 2018 |
| Udgivelsesdato | 26-01-2019 |
| Første udgivelsesår | 2019 |
| Serie | Fungal Biology |
| Illustrationer | 27 Illustrations, color; 5 Illustrations, black and white |
| Fagredaktør | Sachin Kumar, Pratibha Dheeran, Mohammad Taherzadeh, Samir Khanal |
| Originalsprog | Switzerland |
| Sideantal | 246 |
| Indbinding | Paperback / softback |
| Forlag | Springer Nature Switzerland AG |
| Sideoplysninger | 246 pages, 27 Illustrations, color; 5 Illustrations, black and white |
| Mål | 235 x 155 |
| ISBN-13 / EAN-13 | 9783030080020 |

